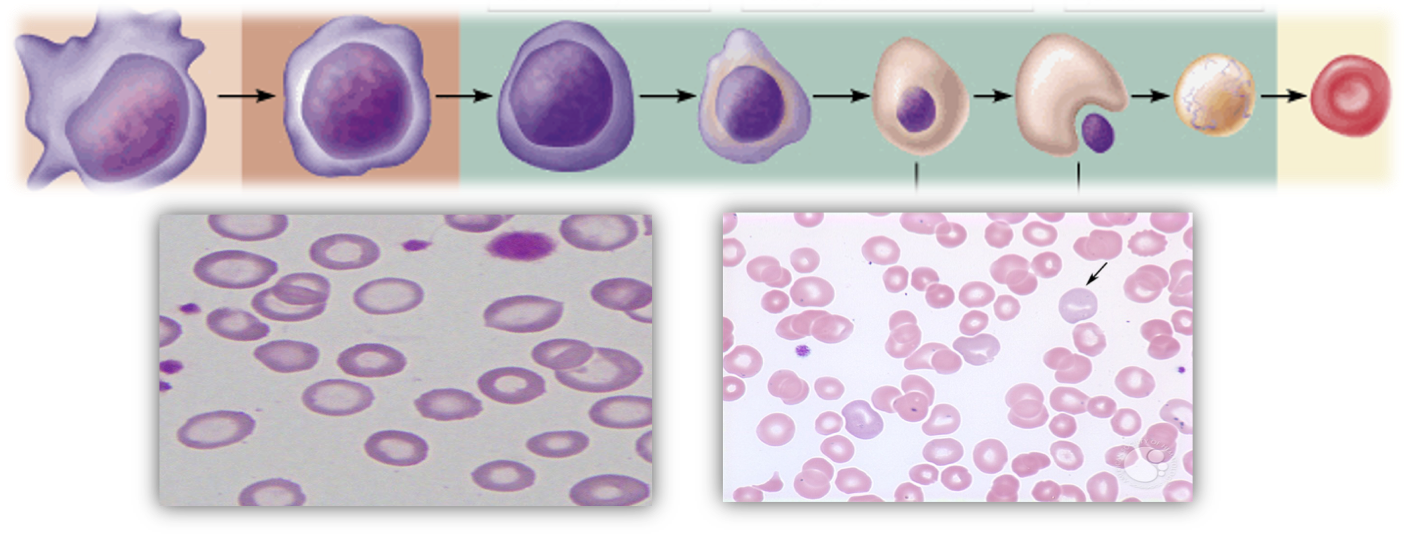

คำอธิบายรายวิชา
โรคที่เกิดจากการเปลี่ยนแปลงทางโลหิตวิทยา โลหิตจาง มะเร็งเม็ดเลือดขาว และการเปลี่ยนถ่ายไขกระดูก
- Teacher: Yutthana Pengjam
- Teacher: THANET PRAJANTASEN
- Teacher: Sirivara Siridamrongvattana
- Teacher: Kanitta Srinoun
- Teacher: Supinya Thanapongpichat